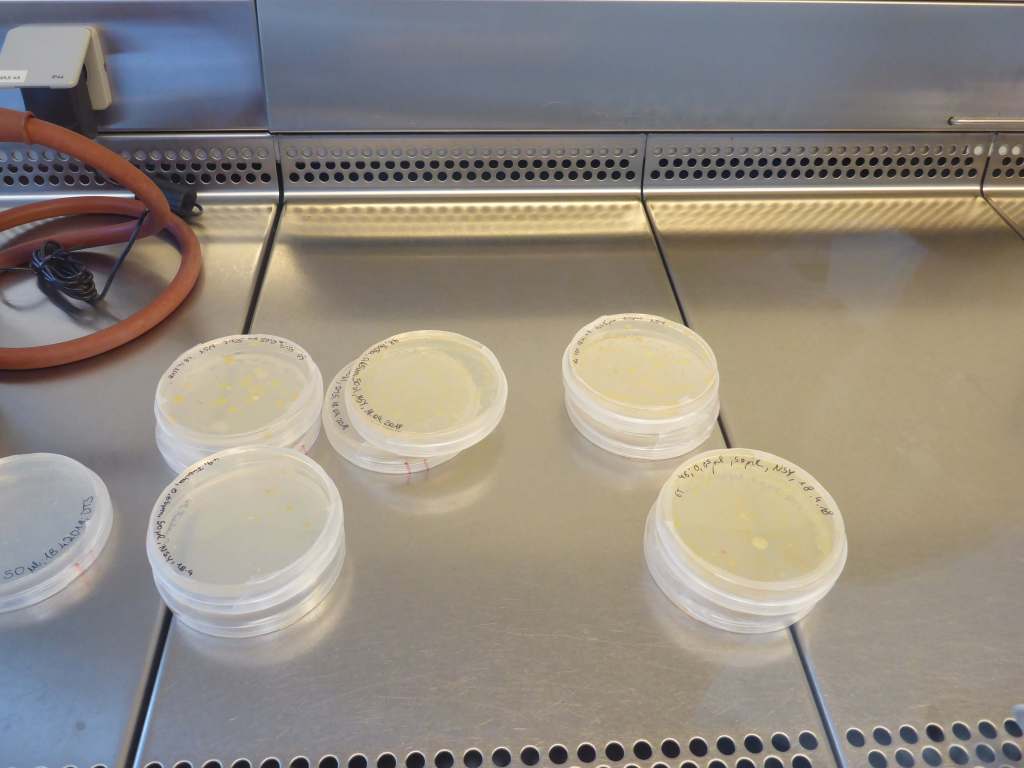
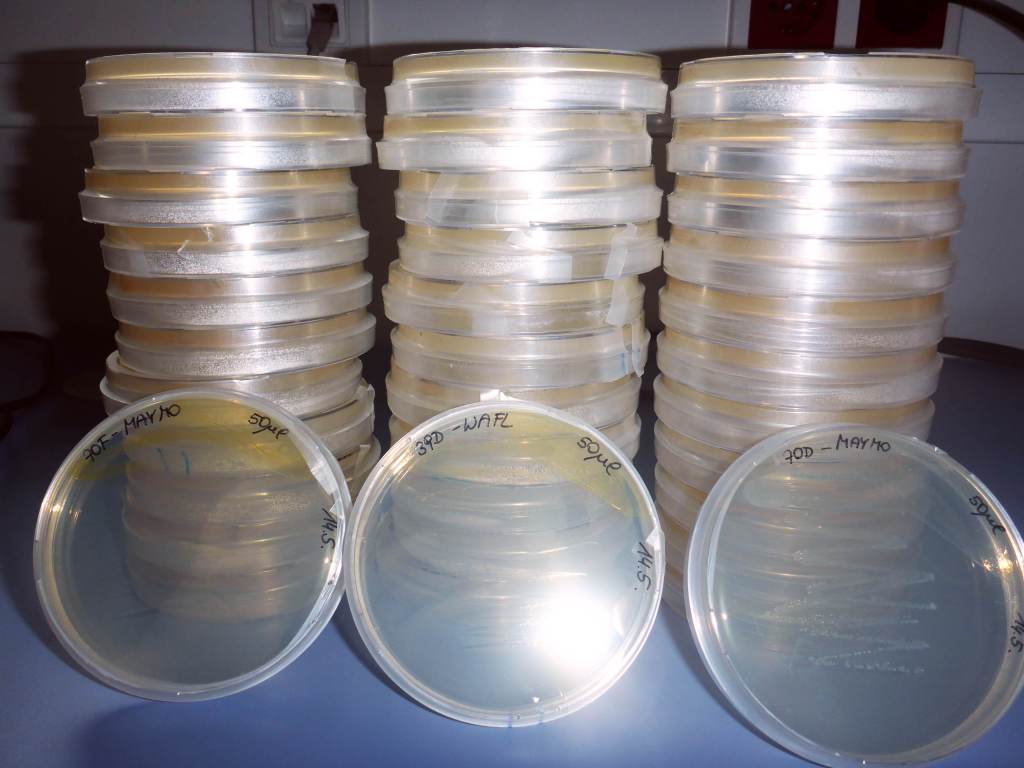

Die von den Schüler/innen bearbeiteten Agarplatten wurden 1 Woche bei Raumtemperatur stehengelassen. Pro Gewässer wurde dann eine Platte mit flüssiger Nährlösung angelegt. Unter der sterilen Werkbank wurden von den Agarplatten einzelne Kolonien vorsichtig mit einem sterilen Zahnstocher abgehoben und in das flüssige Nährmedium gegeben.

Diese Flüssigkulturen wurden dann wieder für eine Woche stehengelassen und überprüft in in welchen Vertiefungen Kulturen angewachsen waren. Erkennen kann man dies daran, dass das Medium trüb wird.


Von diesen Kulturen wurden nun einzeln jeweils 50 µl auf eine Agarplatte pipettiert. Somit entstanden fast 100 einzelne Kulturen von Bakterienstämmen auf Agarplatten.